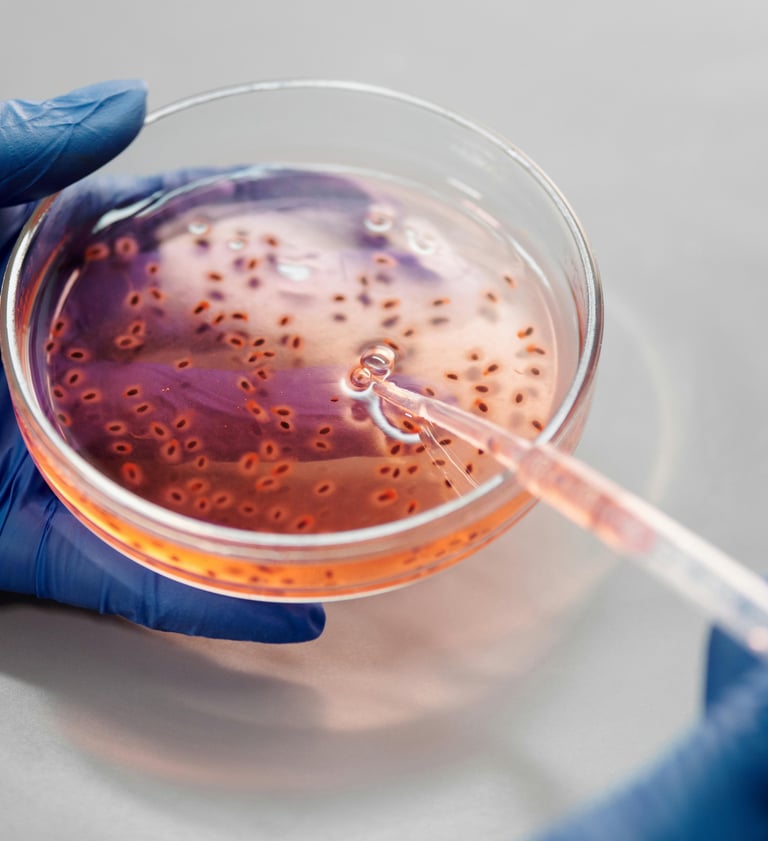
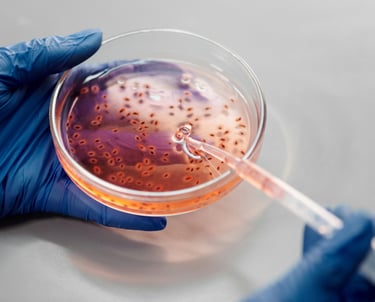

Our marine vinyl








Composition
Thickness
Weight (gn/m²)
Tensile Strength BS EN 13934-1 : 1999
Tearing Resistance BS EN ISO 13934-2
Steam Slippage Resistance BS 3320 : 1998
Abrasion Resistance BS EN ISO 12947-2
Pilling Resistance BS EN ISO 12945-1
Color Fastness to Rubbing BS EN ISO 105X12
Color Fastness to Light BS EN ISO 105 B02
Water Repellent Resistance BS EN 24920 : spray test
Flammability BS 5852 : part 1 smoldering cigarette
Technical Specifications
PVC and Base Cloth
1.4mm
911
PASS
PASS
PASS
200.000
PASS
PASS
6-8
PASS
PASS